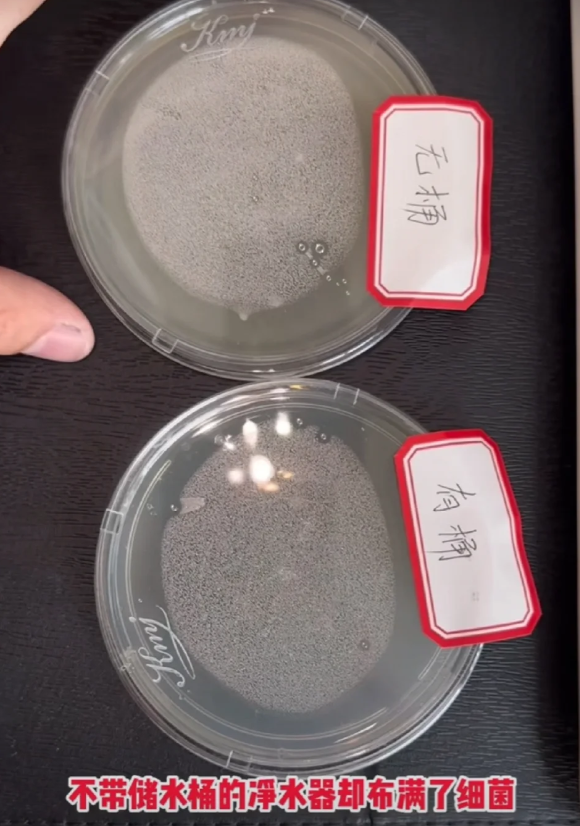

现在的科技进步的太快,家电更新的速度也很快,于是,很多人就以为市场上没有或少见的家电,早已经被时代淘汰了。

殊不知,有些家电之所以在线下较为少见,可能是因为已经转到了线上。

比如下面这5种“很多人以为早已经过时的电器”,实则在线上卖得火爆,再过20年也不会退出中国家庭。

1、投影仪
八零后和九零后小时候都经历过慕天席地看电影的事情,其中不少人都觉得“酷似放映机的投影仪迟早会退出中国家庭。”

但实际上,投影仪虽然存在诸多的缺点,如,受光线的影响,使用寿命远远赶不上电视机,……,实则仍旧备受青睐。

至今仍旧是无数普通家庭和租房党的首选,因为它价格便宜,携带方便,在黑暗中播放的特点对上班族而言,无伤大雅。

所以奉劝大家,别再小看投影仪了。
如果预算有限,居无定所,喜欢大屏幕观影,不如优先考虑一下投影仪。

根据经济实力选择适合的产品,轻而易举的打造家庭影院,自己和家里人在路之余能够更好的放松,观看电视、电影。

2、双缸洗衣机
又名:半自动洗衣机

从名字,大家就可以猜出,这种洗衣机之所以被很多人以为早已经淘汰,很大程度上是因为它无法真正的解放双手,不符合当代年轻人对时间、精力的规划。

然而,实际上,半自动洗衣机仍有市场,依旧是无数家庭必不可少的家电之一。

如,网友@喜辣:专门买回家给孩子洗小衣服被褥的,洗得干净,还高效。

网友@柳儿:新家虽然添置了全自动洗衣机,但这个老古董还是舍不得丢,时不时的还得拿出来用,特别是冬天,洗个棉袄棉裤,洗得又快又干净。

网友@慧声慧色:家里的老人最喜欢用这种洗衣机,上翻盖,可以一边洗一边往里边添衣服,不用弯腰,洗得还干净。

因而,对于预算有限、衣物特别脏的家庭而言,双缸洗衣机仍旧必不可少。

3、欧式油烟机
随着双吸油烟机的出现,欧式油烟机如当初的中式油烟机一样,正逐渐跌下神坛。

为此,越来越多的年轻人装修新房时会优先考虑双吸油烟机或集成灶,以免它们跟不上时代的发展,用一两年就被淘汰。

殊不知,不管是性能还是性价比,欧式油烟机都有可取之处,仍旧是如今的主流。

建议,千万不要盲目的跟风当下的潮流,盲选双吸油烟机或集成灶,以免陷入“装得起,用不起”的困境。

尤其是预算有限的普通家庭,一定要认准欧式油烟机,根据装修以及实际需求在顶吸和侧吸油烟机里二选一。

4、带桶的净水器
桶装水自取麻烦,而且桶装水开封三天后里面就会滋生细菌和异味,可能无法直接饮用,饮用了就会对健康不利。

而安装净水器就没有这样的困扰,于是,越来越多的人优先考虑各种各样的净水器,甚至为了防止出现二次污染的情况,咬牙花大价钱安装一体式净水器。

但其实完全没必要。
和一体式净水器相比,带桶的净水器虽然较为占地方,但经济实惠,制水速度更快,一开水龙头就是净化水。

而且市面上的带桶的净水器价格十分实惠,更适合预算低的普通家庭。

实验表明:带桶的净水器并不存在二次污染的问题,甚至比一些基础款的一体式净水器净化的水质更好,更健康。

因而建议,预算低,有净水需求,同样的价格,不妨优先考虑一下带桶的净水器。

5、方形柜式空调
这种空调,比如今市面上的任何一款空调更占地方,而且只有基础功能。

所以很多人都觉得随着科技的进步,它们肯定早已经被时代淘汰,但实际上,在一些地区它仍旧是很多人的不二之选。

如,网友@ClueNow:找了好久才找到这种比较复古的柜机,虽然看着笨重,但真的很节能,很适合大空间制冷降温。

网友@有何不可:性价比高,省电,送风的距离很远,一台就可以搞定全屋制冷。

网友@累土聚沙:摆在客厅角落,高级又摆搭,和我家的装修风格完美融合,一点都不突兀,关键是性能没得说。

制冷制热速度极快,一般打开十几分钟,吹出的冷气和热气就会快速的充盈全屋,让人感觉舒爽。

所以大家买空调时,如果空间比较大,预算又有限,不如优先考虑一下这种老款的方形柜机空调。

写在最后,
好了,今天就说到这里,谢谢大家的观看、点赞和关注、分享。
部分参考图片来源自网络,未查明出处,如有问题,请私信联系删除。